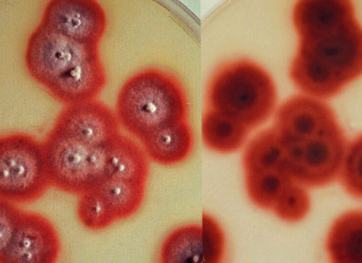
<p></p>
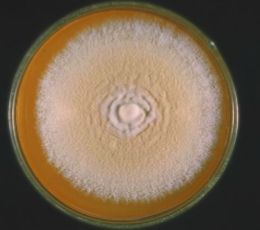
<p></p>
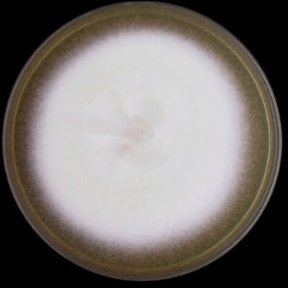
<p></p>
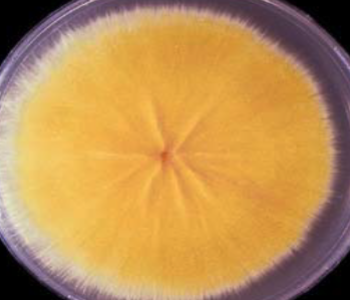
<p></p>
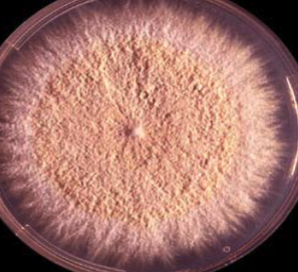
<p></p>
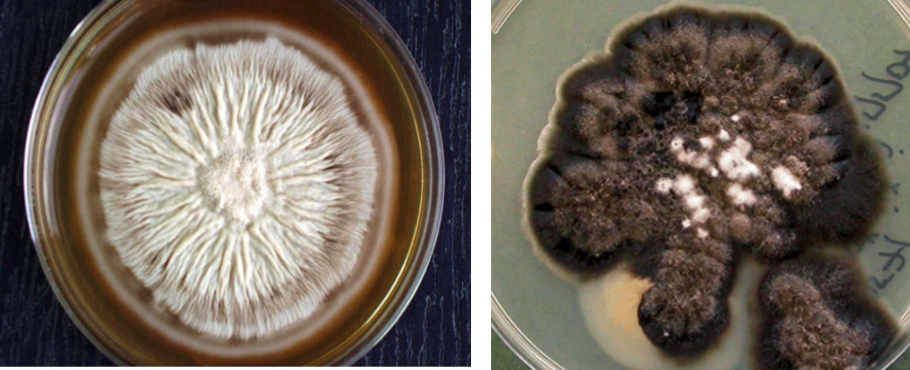
knowt flashcard image

Dermatophytes/Cutaneous Mycoses
1/14
There's no tags or description
Looks like no tags are added yet.
Name | Mastery | Learn | Test | Matching | Spaced | Call with Kai |
|---|
No analytics yet
Send a link to your students to track their progress
15 Terms
Trichophyton rubrum macroscopic
Trichophyton rubrum microscopic
“Picket-fence”

Trichophyton mentagrophytes macroscopic
Trichophyton mentagrophytes microscopic
“grape-like” clusters microconidia

Trichophyton tonsurans macroscopic
Trichophyton tonsurans microscopic
“tear-drop” microconidia

Microsporum canis macroscopic
Microsporum canis microscopic
“spindle-shaped” macroconidia w/ tapered ends

Microsporum gypseum macroscopic
Microsporum gypseum microscopic
“spindle-shaped” macroconidia w/ truncated ends

Epidermophyton floccosum macroscopic

Epidermophyton floccosum microscopic
“beaver-tail” shaped macroconidia

Sporothrix schenckii macroscopic
Sporothrix schenckii microscopic @ 37˚C
“cigar-shaped” yeast cell

Sporothrix schenckii microscopic @ 25˚C
“rosette” or “bouquet of flowers”
